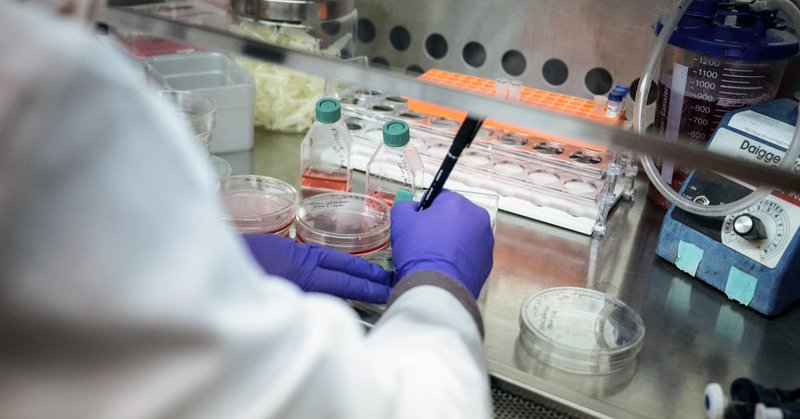
Tweet card summary image

Esther Choo, MD MPH
@choo_ek
Followers
169K
Following
159K
Media
3K
Statuses
67K
Emergency care | mom | research | bylines in MSNBC, WaPo, TIME, USA Today | https://t.co/iS55nZCJqN
Joined January 2012
Live your life so that you cannot accurately be described as exchanging love letters with Kim Jong Un #debate2024
6
29
278
While raising funds for my final year, been applying for jobs, scholarships and studying for the MCAT. It’s a lot—but I’m committed to the journey. 💪🏽 Your support helps me keep going. Please donate or share if you can. https://t.co/hba4ymv2DX
#GoFundMe #MCAT #FutureMD
gofundme.com
Three years ago, I was accepted into my dream school Spelman Colle… Latonja and Taylor Richardson needs your support for Help StarBright Cross the Finish Line
4
6
8
Today we learned the sad news another kid died from measles in Texas. We also learned what RFK Jr. will and will not say And we got a clearer glimpse of the playbook being used to discredit the proven measures to tackle measles outbreaks Let me tell you why I'm worried 🧵
98
1K
5K
Some day in the future, people will wonder why an outbreak ran amok, why a promising cancer therapy didn't make it the last mile, why the safeguards in our communities don't seem to be what they were. And it will trace back to this.
8
8
30
Not papercuts - jugular lacerations. We have lost a generation of scientists and public servants, whose institutional memory and works in progress will be lost to our nation with their abrupt dismissals https://t.co/vomkm2yc3G
bmj.com
The latest mass firings in critical US health services are short sighted, cruel, and ignorant, writes Esther Choo This week is National Public Health Week in the United States and perhaps the saddest...
5
23
53
RIP ❤️ Professor Kiah Duggins was among those lost in the mid-air plane collision at Reagan National Airport. Professor Duggins was set to begin a new chapter as a professor at Howard University School of Law this fall. May her memory be a blessing.
4K
38K
285K
“One well-timed grant can seed a line of sustained inquiry that leads to something meaningful for the health and longevity of Americans; a missed grant can delay or derail that work,” @choo_ek writes. https://t.co/RlV3WkeIcA
ms.now
This is a potentially devastating event — not just for the scientific community, but for all Americans.
1
6
11
My friend and colleague @choo_ek wrote this very nice piece on what it means that the NIH canceled study section meetings and advisory councils last week, and why it is more dangerous than we might think: https://t.co/4eC94vvKIF
#thisispublichealth
ms.now
This is a potentially devastating event — not just for the scientific community, but for all Americans.
3
1
10
My friend, @darakass on @MSNBC commenting on the Trump administration’s rescinding of federal funding freeze! You go girl!🎉 @choo_ek @janevandis
1
3
4
Aw jeez, not this again. According to this consultant, hospitals now *lose* an average of $304,312 per physician per year. 🤦🏻 Guess it’s time for another thread on Budgetary Gerrymandering.
65
263
1K
Last chance to get livestream tickets for tonight's Body Politic: An Evening of Live Storytelling. Tickets are only $25 and you have a FULL WEEK to watch. Don't miss it! https://t.co/8jos0JJHxS
#story #whattowatch
0
4
5
I am beyond honored that my neighbors have chosen me to be the next congresswoman for Oregon’s Fifth Congressional District. I am also proud to be the first – but not the last – Black Member of Congress from Oregon.
233
652
6K
In an ideal scenario the President of the United States and the worst person in the world would be two different people.
1K
19K
208K
If “please let us get emergency abortions” is your ask, you are asking for less than we had BEFORE Roe. I’m not saying this isn’t an important ask, but I am saying that Roe—a middling victory—was achieved by demanding far more.
2
18
110
Rage donate to a local abortion fund Stress donate to a local abortion fund Grief donate to a local abortion fund
16
185
719
If you are putting the blame on protestors for losing this election then you aren’t actually paying attention. Grieve, rest, debrief, strategize, build.
0
12
85
God if I weren’t in the business of health care… But we just keep on weaving the safety nets. What else can we do?
Dems did everything we could to stop him last time. Restrain him. Keep things functioning *as normal.* I don’t think we should this time. He won. This is what the people voted for. This is what people want. They should get it. It’s the only way people will learn.
5
3
71
RFK running DHHS felt as likely as an Onion article until now
10
35
640
If Trump wins, there will be efforts to blame Russian interference or the Harris campaign or Biden, etc. That's all fair. But we need to be clear eyed that a huge swath of America likes what Trump is selling. Transphobia. Mass deportation. That's what he ran on. And here we are.
8K
10K
90K